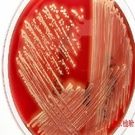
丙酸桿菌科

丙酸桿菌科

丙酸桿菌科,是細菌的1科。本科細菌革蘭氏染色陽性;細胞呈種形態,桿狀或絲狀,不形成真正的分枝;不生芽孢;氧或耐氧,二氧化碳能促進生長;發酵糖產生二氧化碳、丙酸和乙酸,或產生包括丁酸、甲酸、乳酸以及其他羧酸的混合有機酸;在生長所需的有機酸中,乳酸、酸或琥珀酸不是主要組分。
丙酸桿菌科
正文
細菌的 一科。本科細菌革蘭氏染色陽性;細胞呈多種形態,桿狀或絲狀,不形成真正的分枝;不生芽孢;厭氧或耐氧,二氧化碳能促進生長;發酵糖產生二氧化碳、丙酸和乙酸,或產生包括丁酸、甲酸、乳酸以及其他單羧酸的混合有機酸;在生長所需的有機酸中,乳酸、乙酸或琥珀酸不是主要組分。
本科是E.A.德爾維奇於1957年建立的。雖然科內目前僅包括丙酸桿菌屬和真桿菌屬 2屬,但屬內所包括的種卻隨著研究的深入而不斷變動。
丙酸桿菌屬
包括不運動的革蘭氏陽性桿菌,細胞多形態,可呈兩端大小不一的棒狀、類球狀、雙叉狀和分枝狀;細胞排列不一,單個、成對、“八”字形、短鏈或成團塊狀;染色時細胞著色有時較淺,菌苔可呈白、灰、粉紅、紅、黃或橙色;可代謝碳水化合物、蛋白質、丙酮酸或乳酸,發酵產物有丙酸和乙酸,還常有少量的異戊酸、甲酸、琥珀酸或乳酸和二氧化碳;所有的種都同化葡萄糖,需要生長素(如泛酸和生物素等),Tween80有促進生長作用;接觸酶通常陽性;厭氧到耐氧;30~37℃和pH值為7的條件下生長最迅速;通常從蛋白質產生氨,不水解馬尿酸,不還原中性紅;DNA中的G+C克分子含量為59%~66%。丙酸桿菌是乳製品(尤其是乾酪)中的正常菌群,也是人體皮膚的棲息菌,特別是在皮脂腺多的部位(如前額和鼻翼)或汗液多的部位(如腋下等)。也可見於口腔、女性生殖道以及糞便中。丙酸桿菌除在生產乾酪中起作用外,還可用於生產維生素B12。本屬約有20個種和變種,費氏丙酸桿菌為模式種。
真桿菌屬
包括運動的或不運動的革蘭氏陽性桿菌。細胞形態單一或多形;有機化能營養,分解糖或不分解糖,從碳水化合物或蛋白腖產生混合有機酸,包括大量的丁酸、乙酸或甲酸,但不以丙酸、乳酸和乙酸或琥珀酸(有二氧化碳時)為主要產物;厭氧菌,但厭氧程度不一;通常接觸酶陰性。本屬包括很多種,廣泛分布於動物腸道、瘤胃、人類口腔、土壤和水中,也有一些種自病人的病灶分離到。相關連線
百科問答 http://wenda.chinabaike.com/html/20101/q1117098.html